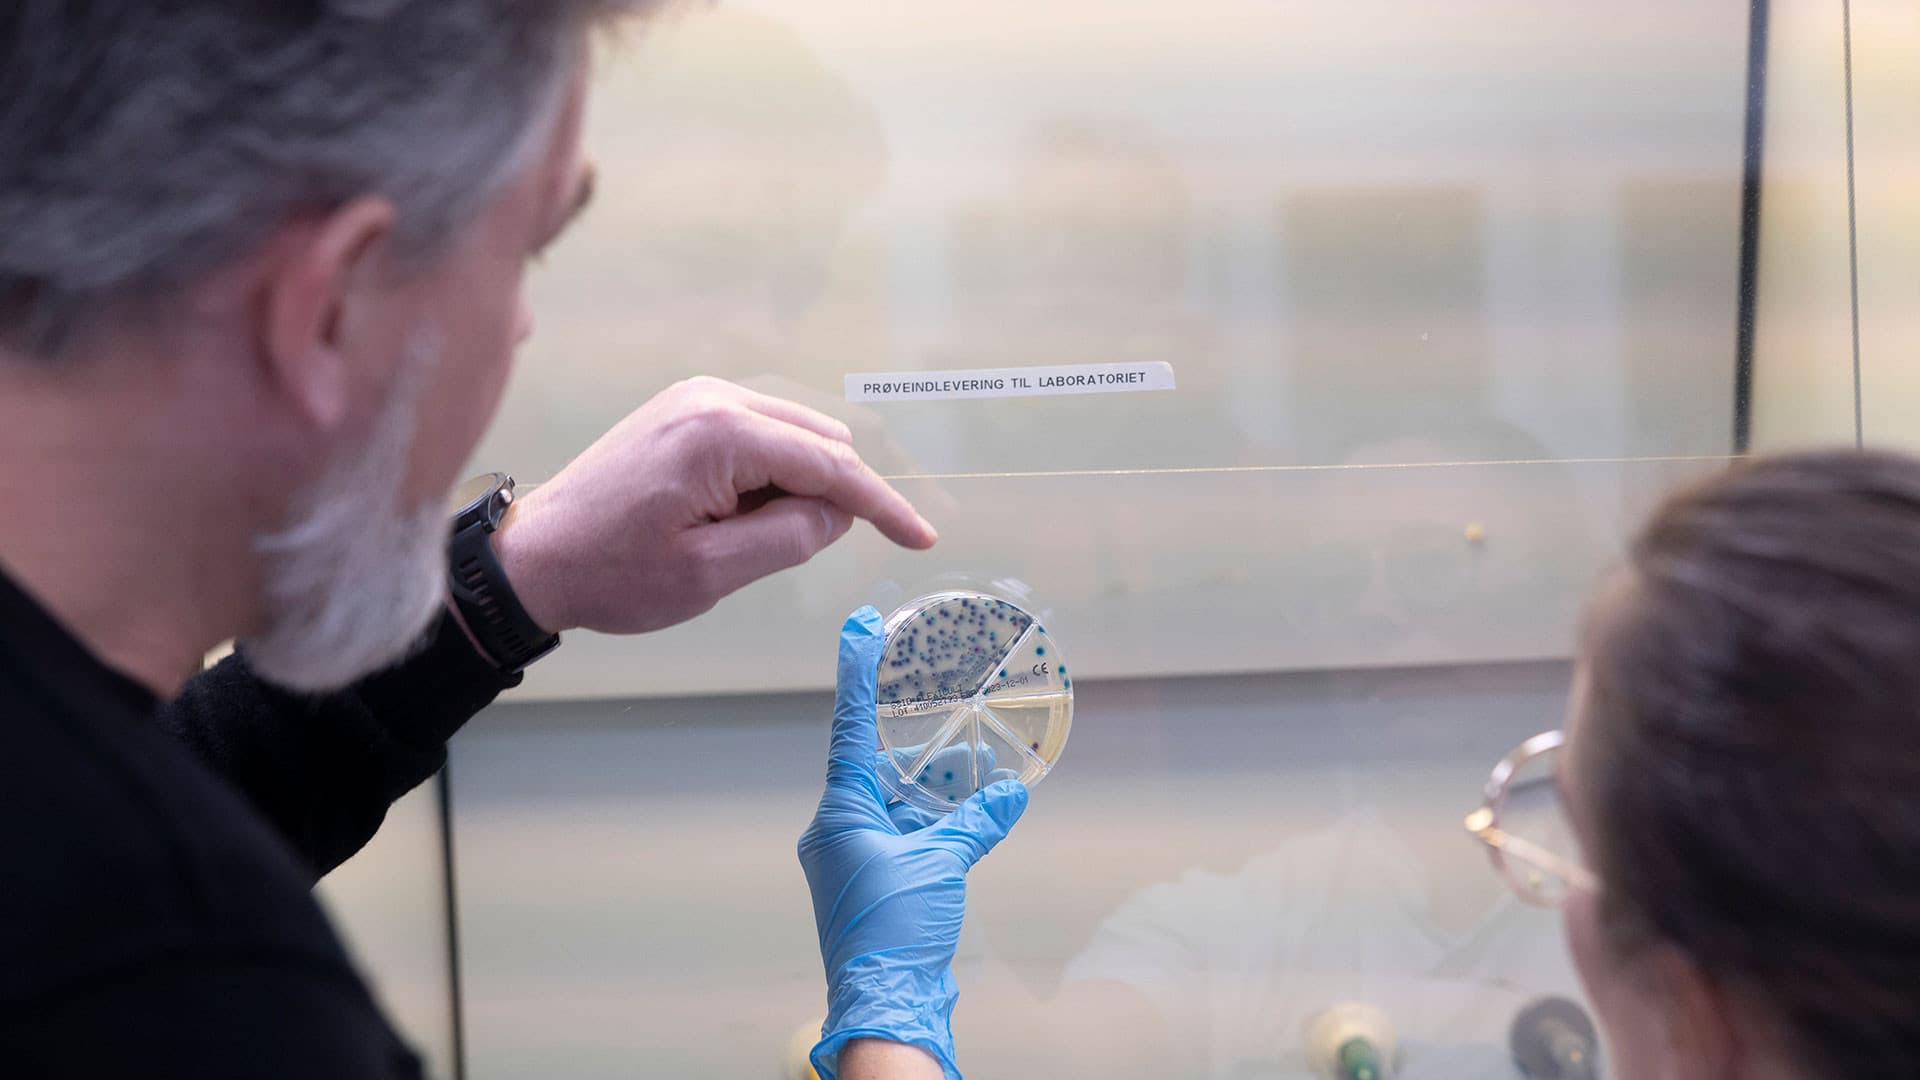

»Solen har ikke været over horisonten i et par uger. Der er kun lys som en tidlig vintermorgen i et par timer på hver side af kl. 13, som er det lyseste tidspunkt, men sneen gør det meget lysere end i Danmark, og her er ingen regn, så det er på ingen måde så mørkt og surt, som det kan være i Danmark. Ilulissat har uden tvivl verdens smukkest beliggende sygehus«. Foto: Klaus Holsting Solen har ikke været over horisonten i et par uger. Der er kun lys som en tidlig vintermorgen i et par timer på hver side af kl. 13, som er det lyseste tidspunkt, men sneen gør det meget lysere end i Danmark, og her er ingen regn, så det er på ingen måde så mørkt og surt, som det kan være i Danmark. Ilulissat har uden tvivl verdens smukkest beliggende sygehus«, siger Kasper Stougaard, ledende regionslæge på sygehuset i nordgrønlandske Illulisat i region Avannaa. Foto: Klaus Holsting